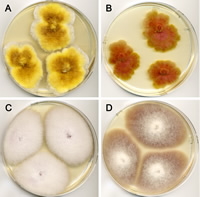
Figure 14

What is a fungus?
A fungus is a eukaryote that digests food externally and absorbs nutrients directly through its cell walls. Most fungi reproduce by spores and have a body (thallus) composed of microscopic tubular cells called hyphae. Fungi are
heterotrophs and, like animals, obtain their carbon and energy from other organisms. Some fungi obtain their nutrients from a living host (plant or animal) and are called
biotrophs; others obtain their nutrients from dead plants or animals and are called
saprotrophs (saprophytes, saprobes).
Some fungi infect a living host, but kill host cells in order to obtain their nutrients; these are called
necrotrophs.
Fungi were once considered to be primitive members of the plant kingdom, just slightly more advanced than bacteria. We now know that fungi are not primitive at all. In fact, recent taxonomic treatments such as the
Tree of Life Project show that fungi and animals both belong to the group Opisthokonta (Fig. 1). Fungi may not be our next of kin, but they are more closely related to animals than they are to plants. We also recognize that organisms traditionally studied as "fungi" belong to three very different unrelated groups: the true fungi in
Kingdom Fungi (Eumycota), the Oomycetes, and the slime molds (Fig. 1).

Figure 1
Let's briefly consider the major groups in Kingdom Fungi—they will be described in greater detail later. Open most introductory mycology books and you'll see that there are four main groups (phyla) of true fungi—Ascomycota,
Basidiomycota,
Chytridiomycota and
Zygomycota (e. g., Alexopoulos et al. 1996; Webster and Weber 2007). Recent studies have provided support for the recognition of additional phyla, such as
Glomeromycota, a group of fungi once placed in Zygomycota that form an association with the roots of most plants (Fig. 2). A group of parasitic organisms called Microsporidia that live inside the cells of animals are also now considered to belong in the fungal kingdom (Fig. 2). Hibbett et al. (2007) published a comprehensive classification of the Kingdom Fungi, the result of collaboration among many fungal taxonomists. This classification is used in the
Dictionary of the Fungi (Kirk et al. 2008) and other fungal references and databases. However, the classification system will undergo additional changes as scientists use new methods to study the fungi. For example, Jones et al. (2011) described the "cryptomycota," a potentially new phylum of organisms within the Kingdom Fungi.

Figure 2
How old are fungi?
Fungi are an ancient group—not as old as bacteria, which fossil evidence suggests may be 3. 5 billion years old—but the earliest fungal fossils are from the Ordovician, 460 to 455 million years old (Redecker et al. 2000). Based on fossil evidence, the earliest vascular land plants didn't appear until approximately 425 million years ago, and some scientists believe that fungi may have played an essential role in the colonization of land by these early plants (Redeker et al. 2000). Mushrooms exquisitely preserved in amber from the Late Cretaceous (94 million years ago) tell us that there were mushroom-forming fungi remarkably similar to those that exist today when dinosaurs were roaming the planet (Hibbett et al. 2003). However, the fungal fossil record is incomplete and provides only a minimum time estimate for when different groups of fungi evolved. Molecular data suggest that fungi are much older than indicated by the fossil record, and may have arisen more than one billion years ago (Parfrey et al. 2011).
How many fungi are there?
No one knows for sure how many species of fungi there are on our planet at this point in time, but what is known is that at least 99,000 species of fungi have been described, and new species are described at the rate of approximately 1200 per year (Blackwell 2011; Kirk et al. 2008). A conservative estimate of the total number of fungal species thought to exist is 1. 5 million (Hawksworth 2001). To come up with this figure, Hawksworth estimated the known numbers of plant and fungal species from countries in which both plants and fungi have been well-studied—Great Britain and Ireland, in this case—and determined there were six fungal species for every native plant species. The total number of plant species worldwide is approximately 250,000, and if the ratio of fungi to plants in Great Britain is typical of what occurs elsewhere, there should be at least 1. 5 million species of fungi (6 × 250,000; Hawksworth 2001).
If 1. 5 million fungal species is a reasonable estimate, the vast majority of all extant fungi are yet to be named. Assuming a relatively constant rate at which new species are described, it will take more than 1100 years to catalog and describe all remaining fungi. However, many of these fungi are likely to become extinct before they are ever discovered given current rates of habitat and host loss. For example, up to 2% of tropical forests are destroyed globally each year (Purvis and Hector 2000). These habitats are exceedingly rich in fungal species (Hawksworth and Rossman 1997). For example, 15-25% of fungi collected in short-term studies in the tropics are new species (Kirk et al. 2008). Callan and Carris (2004) estimated that an 110,000 ha neotropical forest, such as in Costa Rica, could contain over 81,000 different species of plant parasitic fungi—almost as many as
all the known species of fungi! Consider that this estimate was based only on plant parasitic fungi, and did not take into account other ecological groups of fungi such as saprotrophs.
What do fungi do?
Fungi are involved in a wide range of activities—some fungi are decomposers, parasites or pathogens of other organisms, and others are beneficial partners in
symbiosis with animals, plants or algae. Let's take a brief look at these various ecological groups.
Fungi associated with animals
Fungi have the ability to grow on and in both invertebrate and vertebrate animals. Many fungi can attack insects and nematodes, for example, and may play an important role in keeping populations of these animals under control. Insect-attacking fungi, called "entomopathogens," include a wide range of fungi in phyla Ascomycota, Zygomycota and Chytridiomycota. Some of the best-known and most spectacular entomopathogens belong in the Ascomycota genus
Ophiocordyceps and related genera. These fungi infect and consume insects such as caterpillars and ants, and then form conspicuous
stromata that emerge from their victim's body in a most dramatic manner (Fig. 3). These fungi can also alter the insect's behavior. "Zombie-ant" fungi from Brazil infect insect brains, directing the victim to climb up plants and bite into the plant tissue in a "death grip" (Evans et al. 2011; Hughes et al. 2011). Paradoxically, humans have been using one of these entomopathogens,
Ophiocordycepssinensis, for thousands of years to treat a wide range of ailments. This fungus is an important component of traditional Asian medicine (Fig. 3) and is commonly called "winter worm, summer grass. "

Figure 3
Entomopathogens such as
Beauveriabassiana are so effective in killing insects that they are used as
biological control agents for insect pests. Colony collapse disorder of honeybees has been associated with co-infection by a virus and a microsporidian fungus,
Nosema ceranae (Bromenshenk et al. 2010). One group of fungi called Entomophthorales ("insect killers") includes a number of highly specialized entomopathogens. A common example is
Entomophthora musae, which is often observed forming a ring of white spores discharged around the body of a parasitized fly on panes of glass.
Some fungi are specialized parasites of nematodes, rotifers, and other microscopic animals in the soil (Barron 1977). A common nematode predator is
Arthrobotrys oligospora, a fungus that has evolved sticky networks of hyphae for trapping nematodes. Once the nematode is immobilized, the fungus invades and consumes its body.
Fortunately, there are relatively few fungal pathogens of vertebrates—only 200-300 species—but some of these fungi can have devastating impacts. Consider the well-publicized frog killer,
Batrachochytrium dendrobatidis, a member of phylum Chytridiomycota (Berger et al. 1998; Longcore et al. 1999). This fungus wasn't even known to scientists until 1996, when it was discovered associated with frogs that had died from a mysterious skin disease at the Smithsonian National Zoological Park in Washington, D. C. The fungus doesn't invade the frog's body, but it is lethal, possibly because it disrupts electrolyte balance leading to cardiac arrest (Voyles et al. 2009)—infected frogs appear to die of a heart attack! The frog chytrid is implicated in the widespread decline of frog populations around the world. Fortunately, this is the only chytrid known to parasitize a vertebrate animal and it appears to infect only amphibians.
Another devastating parasite of animals is
Geomyces destructans, a cold-loving fungus that causes 'white-nose syndrome' in bats (Blehert et al., 2009). This fungus colonizes the skin on the muzzles, ears and wing membranes of some types of bats, and infected bats exhibit unusual behavior. The bat fungus is associated with declines in bat populations in the northeastern U. S. and has many wildlife biologists concerned. As of 2011, white-nose syndrome had been confirmed in 16 states and four Canadian provinces.
In humans, there are several different types of fungal infections, or "mycoses. " The most common are caused by dermatophytes, fungi that colonize dead keratinized tissue including skin, finger-, and toenails. Dermatophytes cause superficial infections such as 'ringworm' that are unsightly and difficult to treat, but rarely serious. Some fungi are members of the resident microflora in healthy people, but become pathogenic in people with predisposing conditions. For example,
Candida species cause annoying yeast infections in the mucosal tissues of many healthy people, but can also cause diseases collectively called candidiasis in babies and immunocompromised individuals.
Another group of fungi are inhaled as spores and initiate infection through the lungs. These fungi include
Coccidioides immitis (coccidioidomycosis, commonly known as valley fever), and
Histoplasma capsulatum (histoplasmosis). Opportunistic fungal pathogens are normally not associated with humans and other animals, but can cause serious infections in weakened or healthy individuals when inhaled or implanted in wounds.
Aspergillus fumigatus, one of the most important of these opportunists, produces small, airborne spores that are frequently inhaled; in some individuals the fungus starts growing invasively, causing a disease known as aspergillosis, especially in immunocompromised individuals.
A remarkable discovery was that
Pneumocystis carinii, the organism causing pneumonia-like symptoms in immunocompromised patients, is a fungus and not a protozoan as had been thought for decades. Why was this pathogen classified as a protozoan? It does not respond to the common drugs used to treat fungal infections, but does respond to anti-protozoan drugs. This unusual fungus emerged as one of the leading causes of death in AIDS patients in the late twentieth century.
Fungi and plants
The association of fungi and plants is ancient and involves many different fungi. Fungi are an important group of plant pathogens—most plant diseases are caused by fungi—but fewer than 10% of all known fungi can colonize living plants (Knogge, 1996). Plant pathogenic fungi represent a relatively small subset of those fungi that are associated with plants. Most fungi are decomposers, utilizing the remains of plants and other organisms as their food source. Other types of associations that will be discussed here include the role of fungi as decomposers, as beneficial symbionts, and as cryptic plant colonizers called
endophytes.
Most fungi are associated with plants as saprotrophs and decomposers. These fungi break down organic matter of all kinds, including wood and other types of plant material. Wood is composed primarily of cellulose, hemicellulose, and lignin. Lignin is a complex polymer that is highly resistant to degradation, and it encrusts the more readily degradable cellulose and hemicellulose. Fungi are among the few organisms that can effectively break down wood, and fall into two main types—brown and white rot fungi.
Brown rot fungi selectively degrade the cellulose and hemicellulose in wood, leaving behind the more recalcitrant lignin. The decayed wood is brown in color and tends to form cubical cracks due to the brittle nature of the remaining lignin (Fig. 4). Only ~10% of the wood decay fungi cause brown rot, and most of these fungi (80%) occur on conifer wood. Brown rot residues make up 'humus' in temperate forest soils and are important for mycorrhizal formation (see the following paragraph for information on mycorrhizal fungi), moisture retention, and for sequestering carbon. Brown rot residues are highly resistant to decomposition and can remain in the soil for up to 300 years.
White rot fungi are more common than brown rot fungi; these fungi degrade cellulose, hemicellulose, and lignin at approximately equal rates. The decayed wood is pale in color, light in weight, and has a stringy texture (Fig. 5). White rot fungi are the only organisms that can completely degrade lignin. Lignin is one of the most abundant organic polymers, accounting for 30% of the organic carbon on the planet—only cellulose is more abundant (Boerjan et al. 2003).

Figure 4 |

Figure 5 |
An important group of fungi associated with plants is mycorrhizal fungi. Mycorrhiza means 'fungus root', and it refers to a mutually beneficial association (a type of symbiosis) between fungi and plant roots. There are seven major types of mycorrhizal associations, the most common of which is the arbuscular mycorrhizae, involving members of phylum Glomeromycota associated with roots of most major groups of plants. The vast majority (>80%) of vascular plants form mycorrhizae, as will be discussed later (under Glomeromycota).
Another common type of association is
ectomycorrhizae formed between forest trees and members of phyla Basidiomycota and Ascomycota. In this association, the fungus forms hyphae around host root cortical cells—the "Hartig net"— and a sheath of hyphae around the host roots called a "mantle. "Many of the ectomycorrhizal fungi are mushroom-forming species including highly prized edibles such as chanterelles (Cantharellus cibarius and related species), boletes (Boletus edulis and related species), and matsutake (Tricholomamagnivelare) (Fig. 6). A valuable group of ectomycorrhizal fungi are truffles, members of phylum Ascomycota that form underground fruiting bodies. The French Périgord truffle,
Tuber melanospora, and the Italian white truffle,
Tubermagnatum, can bring phenomenal prices; for example, a 1. 5-kg Italian white truffle sold for $330,000 at an auction in 2007!

Figure 6
Lichens are examples of a symbiotic association involving a fungus and green algae or less frequently Cyanobacteria. The lichen thallus is composed mostly of fungal hyphae, usually with the alga or cyanobacterium confined to discrete areas of the thallus. In lichens, reproductive structures of the fungus are often conspicuous, for example disc- or cup-like structures called
apothecia (Fig. 7). The fungus obtains carbohydrates produced by photosynthesis from the algae or cyanobacteria, and in return provides its partner(s) with protection from desiccation and ultraviolet light. Lichens grow in a wide range of habitats on nearly every continent. Think about an inhospitable place, and there's probably a lichen that grows there—on bare rocks, sidewalks, grave stones, the exoskeletons of some insects, and even on cars that remain for a long time in one place!

Figure 7
Some fungi are hidden inside their plant hosts; these are
endophytes, defined by their presence inside asymptomatic plants. All plants in natural ecosystems probably have some type of symbiotic association with endophytic fungi (Rodriguez et al. 2009). Endophytic fungi have been shown to confer stress tolerance to their host plant, for example, to disease, herbivory, drought, heat, salt and metals. The clavicipitaceous endophytes in the genus
Neotyphodium (phylum Ascomycota) are among the best studied. These fungi produce alkaloid compounds that protect the grass host from insects that would otherwise feed on them; endophyte-infected turfgrass seed is sold commercially for seeding lawns and other types of grassy recreational areas. Unfortunately, livestock such as sheep, cattle, llamas and horses also are negatively affected by toxins produced by endophytes when they eat infected grass. 'Ryegrass staggers' occurs when animals graze on perennial ryegrass (Lolium perenne) that is colonized by
Neotyphodium lolii. Afflicted animals develop symptoms including tremors and jerky or uncoordinated movements.
Let's now consider the role of fungi as plant pathogens. There are thousands of species of plant pathogenic fungi that collectively are responsible for 70% of all known plant diseases. Plant pathogenic fungi are parasites, but not all plant parasitic fungi are pathogens. What is the difference between a parasite and a pathogen? Plant parasitic fungi obtain nutrients from a living plant host, but the plant host doesn't necessarily exhibit any symptoms. In this sense, endophytic fungi discussed in the preceding paragraph are plant parasites because they live in intimate association with plants and depend on them for nutrition. Plant pathogenic fungi are parasites and cause disease characterized by symptoms.
Biotrophic fungal pathogens obtain nutrients from living host tissues, often via specialized cells called
haustoria that form inside host cells (Fig. 8). Necrotrophic pathogens obtain nutrients from dead host tissue, which they kill through the production of toxins or enzymes. Most biotrophic fungi have fairly narrow host ranges—they are specialized on a limited number of plant hosts. Necrotrophic fungi can be either generalists, growing on a wide range of host species, or specialized on a restricted range of hosts. Some plant pathogenic fungi change the way that their hosts grow, either by affecting the level of growth regulators produced by the plant, or by producing growth regulators themselves. Examples of changes in plant growth caused by plant pathogenic fungi include
cankers,
galls,
witches' broom, leaf curl and
stunting.

Figure 8
We can further divide plant pathogenic fungi by the stage of the plant host that is attacked, for example, seeds, seedlings, or adult plants, and by what part of the plant is affected—roots, leaves, shoots, stems, woody tissues, fruits or flowers. A group of fungi including species of
Fusarium,
Rhizoctonia and
Sclerotium cause seed rot and infect plants at the seedling stage. These pathogens can attack a wide range of plants. Often, seedling pathogens cause
damping-off symptoms because they occur in wet soils.
Many of the same fungi that kill seedlings can also infect the roots of mature plants and cause root and crown rot diseases. Infection often occurs through wounds, and results in lesions or death of part or all of the root system and crown. Some common root rots of trees are caused by members of phylum Basidiomycota in the genera
Armillaria and Heterobasidion.
Armillaria spp. produce shoe-string-like bundles of hyphae called
rhizomorphs that allow the fungus to grow from one tree to another. Species of
Heterobasidion survive as saprotrophs in dead tree stumps and roots, but can also infect living hosts through root contact. These fungi cause decay in the roots and crown; infected trees become weakened and die, or may blow over in high winds. Wood rot fungi, most of which are also members of Basidiomycota, infect trees through wounds, branch stubs and roots, and decay the inner heartwood of living trees. Extensive decay weakens the tree, and reduces the quality of wood in trees harvested for timber (see the discussion of "white rot" and "brown rot" fungi above).
Vascular wilt pathogens kill their host by infecting through the roots or through wounds and growing into the xylem, where they produce small spores that get carried upward until they are trapped at the perforated ends of the xylem vessels. The spores germinate and grow through the pores. The fungus is transported throughout the plant in this manner. The first symptom of vascular wilt is a loss of
turgidity in the plant leaves, often on one side of the plant or a single branch. If the stems of infected plants are cut open, vascular discoloration is evident. Among the important vascular wilt fungi are
Fusarium oxysporum,
Verticillium albo-atrum and V. dahliae.
One of the most famous vascular wilts is
Panama disease of bananas, caused by
Fusariumoxysporum forma specialis (f. sp. )
cubense. This fungus nearly wiped out banana production in Latin America in the early twentieth century. Most bananas that were being grown for export were a single cultivar, 'Gros Michel', which turned out to be highly susceptible to Panama disease. There is no effective method for controlling Panama disease and it rapidly spread throughout banana plantations around the world. The banana industry was saved by the discovery of the cultivar 'Cavendish' that is resistant to the strain of Panama disease that killed 'Gros Michel'. 'Cavendish' is now the banana that Americans and Europeans consume, but a new strain of the Panama disease pathogen began killing 'Cavendish' in Malaysia in 1985 and scientists are concerned that this strain will begin to spread (Ploetz, 2005).
Leaf spot pathogens infect through natural plant openings such as stomates or by penetrating directly through the host cuticle and epidermal cell wall. In order to penetrate directly, fungi produce hydrolytic enzymes—cutinases, cellulases, pectinases and proteases—for breaking down the host tissue. Alternatively, some fungi form specialized structures called
appressoria (sing. appressorium) at the end of
germ tubes. Turgor pressure builds up in the appressorium, and in combination with an
infection peg, mechanical force is exerted to breach the host cell walls. Once inside the plant leaf, the fungus must obtain nutrients from the cells, and this is often accomplished by killing host cells (necrotrophs). Death of host cells is evident as an area of dead cells called a
lesion (Fig. 9).

Figure 9
Many leaf-spotting fungi produce
toxins that kill host cells and this often produces a lesion surrounded by a yellow halo (Fig. 10). If enough of the leaf surface is killed, or if the infected leaves drop prematurely, the plant's ability to produce photosynthates is severely impaired.

Figure 10
Returning to bananas, another devastating disease of this host is black leaf streak, or
black Sigatoka, caused by
Mycosphaerella fijiensis. Unlike the root-infecting pathogen that causes Panama disease, the black Sigatoka pathogen can be controlled by applications of a protective fungicide to banana leaves. Effective control of black Sigatoka requires multiple fungicide applications and control of this disease accounts for up to 25% of the total production cost for bananas (Ploetz, 2001).
American chestnut trees were once a prominent hardwood tree in the eastern U. S., but have largely been eliminated by the chestnut blight pathogen,
Cryphonectriaparasitica, an example of a canker-causing fungal pathogen.
Cankers develop when the pathogen kills the phloem and vascular cambium in a woody host. If the canker encircles the trunk or branch of a tree, that plant part will die. The canker-causing fungus can often be identified based on the fruiting bodies that form in the canker. In contrast to cankers,
galls result from abnormal growth of a plant, usually due to an increase in cell size and cell division. Although galls are often associated with insect pests, some fungal pathogens induce galls; two common examples are the
black knot pathogen,
Apiosporinamorbosa on
Prunus spp. (Fig. 11), and species of
Gymnosporangium, which induce the formation of galls on their coniferous hosts (Fig. 12).

Figure 11 |

Figure 12 |
Gymnosporangium is a type of rust fungus.
Rust fungi are biotrophic pathogens—they infect, grow, and sporulate in living plant tissue. Even though biotrophs require living host tissue for their growth and reproduction, they can be devastating pathogens by reducing the photosynthetic surface and increasing water loss in the host plant. Rust fungi attack a wide range of plants, and often require two, unrelated hosts in order to complete their life cycles. Rust fungi are so-named because of the abundant orange spores that are formed on plants that are infected by these fungi; infected plants often look as though they are rusting.
One historically important rust fungus is black stem rust of wheat, a disease that was well known to the ancient Romans.
Black stem rust, caused by
Pucciniagraminis f. sp.
tritici, infects wheat and barberry (Berberis species). Since the barberry host is required for the pathogen to complete its life cycle, early control measures in the United States and Canada were aimed at eliminating this host, not the economically important host, wheat. We now know that this method of eradication was of limited success because rust spores can be carried long distances—for example, from northern Mexico to the U. S. -Canada border—by wind currents via the "Puccinia pathway" (Nagarajan and Singh 1990).
Morphological characteristics of fungi:mycelium and hyphae
Now let's take a closer look at fungi and the types of structures that they form. A key characteristic of fungi that has contributed to their successful exploitation of diverse ecological niches is the formation of a filamentous thallus called the
mycelium. A mycelium is composed of branching, microscopic tubular cells called
hyphae (Fig. 13) that grow through and across substrates or food sources, secreting enzymes that break down complex substrates into simple compounds that can be absorbed back through the cell wall. The fungal cell wall in the Kingdom Fungi is composed of chitin and glucans (in Ascomycota, Basidiomycota and Chytridiomycota) as well as chitosan and other components (in Zygomycota) (Kirk et al., 2008)

Figure 13
Hyphae can have cross walls called
septa, or lack cross walls (nonseptate; aseptate; coenocytic). The type of hyphae—septate or
aseptate—is characteristic of specific groups of fungi. In fungi that form septate hyphae, there are perforations at the septa, called septal pores, which allow the movement of cytoplasm and organelles from one compartment to the next. The type and complexity of the septal pore is characteristic of specific groups of fungi.
Hyphae grow from a germinating spore or other type of propagule, and these are described in more detail in the section "Fungal Reproduction. "Hyphae elongate almost exclusively at the tips, growing outwards from the point of establishment. As a result of apical growth, hyphae are relatively uniform in diameter, and mycelium that grows in an unimpeded manner forms a circular colony on solid substrates that support fungal growth; agar, a gelatinous material derived from seaweed, amended with different types of nutrients is commonly used to grow fungi in culture (Fig. 14).
Figure 14
Some fungi grow exclusively or mostly as
yeasts, defined as single-celled fungi that reproduce by budding or fission. In contrast to apical growth that is characteristic of hyphae, yeasts exhibit wall growth over the entire cell surface, often resulting in a nearly spherical cell (Fig. 15). There are also fungi that can switch between mycelial growth and yeast-like growth, dependent upon the environmental conditions. The ability to grow in different forms is called dimorphism, and is exhibited by some members of phyla Ascomycota, Basidiomycota and Zygomycota.

Figure 15
Inside the fungal cell
Most of the organelles present in fungal cells are similar to those of other eukaryotes. Fungal nuclei are usually small (< 2 µm diameter), and can compress and/or stretch to move through septal pores and into developing spores. Fungi have been found to possess between 6 and 21 chromosomes coding for 6,000 to nearly 18,000 genes. Genome sizes range from 8. 5 megabase pairs (Mb) to just over 400 Mb in filamentous fungi (Zolan 1995; Spanu et al. 2010; Duplessis et al. 2011), making fungal genomes among the smallest of eukaryotic organisms on average—approximately 1% the size of mammalian genomes and only 1. 3 times the size of the largest known bacterial genome (Stover et al. 2000). Many fungi (Ascomycota) have a life cycle that is predominantly haploid, while others (Basidiomycota) have a long
dikaryotic phase.
Fungal reproduction
Fungi frequently reproduce by the formation of spores. A spore is a survival or dispersal unit, consisting of one or a few cells, that is capable of germinating to produce a new hypha. Unlike plant seeds, fungal spores lack an embryo, but contain food reserves needed for germination. Many fungi produce more than one type of spore as part of their life cycles. Fungal spores may be formed via an asexual process involving only mitosis (mitospores), or via a sexual process involving meiosis (meiospores). The manner in which meiospores are formed reflects the evolutionary history and thus the classification for the major groups (phyla) of fungi.
Many fungi produce spores inside or upon a fruiting body. Many people are familiar with the mushroom, a type of fruiting body produced by some Basidiomycota. You may recognize other fungal fruiting bodies such as puffballs, or shelf fungi. These are examples of large, conspicuous fruiting bodies, but there is an even greater diversity of microscopic fruiting bodies produced by various fungi. What all fruiting bodies have in common is that they produce spores and provide a mechanism for dispersing those spores. Fruiting bodies will be discussed in more detail within the fungal groups.
Teleomorph and anamorph
Many fungi are able to reproduce by both sexual and asexual processes. Sexual and asexual reproduction may require different sets of conditions (e. g., nutrients, temperature, light, moisture). In some fungi, two sexually compatible strains must conjugate (mate) in order for sexual reproduction to occur. The terms 'anamorph' and 'teleomorph' are used to convey the asexual and sexual reproduction morphological types, respectively, in a particular fungus. The concept of anamorph and teleomorph is a confusing one for many students, as we are not accustomed to thinking about organisms with such reproductive flexibility. For a more thorough discussion of anamorph and teleomorph, refer to Alexopoulos et al. (1996), Kendrick (2000), or Webster and Weber (2007).
Meiospores
Examples of meiospores—spores that are the products of meiosis—include
ascospores (see Ascomycota) and
basidiospores (see Basidiomycota). Ascospores are formed inside a sac-like structure called an
ascus (Fig. 16). An ascus starts out as a sac of cytoplasm and nuclei, and by a process called "free cell formation" (Kirk et al. 2008) a cell wall forms de novo around each nucleus and surrounding cytoplasm to form ascospores (typically eight per ascus). Ascospores vary in size, shape, color, septation, and ornamentation among taxa. Basidiospores are formed on a
basidium (Fig. 17) and are typically one-celled with one or two haploid nuclei. Basidiospores vary in size, color and ornamentation depending upon the taxonomic group. More information on dispersal of ascospores and basidiospores can be found below.

Figure 16 |

Figure 17 |
Mitospores
Examples of mitospores are
conidia (sing. conidium),
sporangiospores, and
zoospores, formed by members of the phyla Ascomycota, Zygomycota, and Chytridiomycota, respectively. Another type of asexual propagule produced by fungi in several different phyla is the
chlamydospore
Conidia
Conidia are formed from a modified hypha or a differentiated
conidiogenous cell of the fungus. Conidiogenous cells can be formed singly on hyphae, on the surface of aggregated hyphal structures, or within different types of fruiting bodies. Fruiting bodies inside which conidia are formed are
pycnidia and
acervuli.
Sporodochia and
synnemata are examples of fruiting bodies on which conidia are formed. Conidia are produced primarily by Ascomycota, although some Basidiomycota are capable of producing them as well.
Sporangiospores
Sporangiospores are asexual propagules formed inside a globose or cylindrical
sporangium by a process involving cleavage of the cytoplasm. Sporangiospores are thin-walled, one-celled, hyaline or pale-colored, and are usually globose or ellipsoid in shape. One to 50,000 sporangiospores may be formed in a single sporangium. When mature, sporangiospores are released by breakdown of the sporangial wall, or the entire sporangium may be dispersed as a unit. Sporangiospores are produced by fungi in phyla Chytridiomycota and Zygomycota, as well fungal-like Oomycetes (see section "Fungal-like Organisms Studied by Plant Pathologists and Mycologists").
Zoospores
A
zoospore is a microscopic, motile propagule, approx. 2 to 14 µm long and 2 to 6 µm in diameter that lacks a cell wall and is characterized by having one or more
flagella. Flagella are ~ 0. 25 µm in diameter and up to 50 µm long. Zoospores are produced by one group of true Fungi (Chytridiomycota), and by fungal-like organisms in Kingdom Straminipila and some slime molds (see section "Fungal-like Organisms Studied by Plant Pathologists and Mycologists"). Two types of flagella are known—the whiplash flagellum, which is directed backward, and the tinsel flagellum, which is directed forward. The tinsel flagellum is only present in members of Kingdom Straminipila and does not occur in true fungi. The length of time zoospores are able to swim is determined by their endogenous energy reserves—zoospores cannot obtain food from external sources—and environmental conditions. Zoospores may exhibit chemotaxis—movement in response to a chemical gradient, e. g., root exudates. At the end of its motile phase, the zoospore undergoes a process called encystment in which it either sheds or retracts the flagella and produces a cell wall. The encysted zoospore, called a cyst, may germinate directly by the formation of a
germ tube, or indirectly by the emergence of another zoospore.
Zoospores are formed inside a sac-like structure called a
zoosporangium by a process involving mitosis and cytoplasmic cleavage—similar to the formation of sporangiospores in sporangia. Depending upon the taxonomic group, zoospores emerge from the zoosporangium through breakdown of the zoosporangial wall, through a preformed opening in the wall covered with a cap called an operculum that flips back, or by a gelatinous plug that dissolves.
Chlamydospores
Chamydospores are survival propagules formed from an existing hyphal cell or a conidium that develops a thickened wall and cytoplasm packed with lipid reserves. The thickened cell walls may be pigmented or hyaline, and chlamydospores develop singly or in clusters, depending upon the fungus. Chlamydospores are passively dispersed, in most instances when the mycelium breaks down. Chlamydospores are formed by many different groups of fungi and are often found in aging cultures.
Sclerotia
Sclerotia (sing. sclerotium) are compact aggregations of hyphae differentiated into an outer, pigmented rind, and an inner mass of hyaline cells called a medulla. Sclerotia contain food reserves, and are a type of survival propagule produced by a number of fungi in phyla Ascomycota and Basidiomycota; in some fungi, such as
Rhizoctoniasolani, they are the only type of propagule produced, whereas in fungi such as
Claviceps purpurea and
Sclerotinia sclerotiorum, they are overwintering structures that can germinate directly, or give rise to structures in which the meiospores are formed.
Kingdom Fungi
The characteristics and diversity of the major phyla of true Fungi will be briefly described. Selected representatives of the different phyla are introduced and, in many instances, illustrated. A generalized life cycle also is presented for each phylum that illustrates when plasmogamy (cell fusion), karyogamy (nuclear fusion) and meiosis occur relative to each other, and the types of structures involved in these events. For more detailed information on members of Kingdom Fungi, recommended reading is provided at the end of this article.
Phylum Ascomycota is the largest group of fungi, with approximately 33,000 described species in three subphyla—Taphrinomycotina, Saccharomycotina, and Pezizomycotina. Members of this phylum reproduce sexually or meiotically (Fig. 18 – general life cycle) via production of
ascospores inside a sac-like structure called an
ascus (Fig. 19).

Figure 18 |

Figure 19 |
Many species of Ascomycota also (or exclusively) produce spores through an asexual or mitotic process; these spores, called
conidia, exhibit a wide range of size, shape, color and septation among the different fungi in which they are formed. Conidia and ascospores are usually produced at different times of year, if ascospores are formed in the lifecycle. The existence of many Ascomycota having sexual and asexual states that are separated in time and space has long confused those new to mycology and plant pathology. The asexual states of Ascomycota are especially important to the plant pathologist because they are more commonly encountered than the sexual state, and must be identified for control, quarantine, or other purposes. Fungi that reproduce only via asexual means have been given various designations including deuteromycetes, fungi imperfecti, mitosporic fungi, conidial fungi, and anamorphic fungi.
Subphylum Taphrinomycotina includes fungi that, with one known exception, do not form fruiting bodies—as examples, the fission yeast
Schizosaccharomyces (Fig. 20), plant parasites in the genera
Protomyces and
Taphrina (peach leaf curl; see Figs. 21 & 22), and
Pneumocystis, a yeast-like fungus previously mentioned (in "Fungi associated with animals") that causes pneumonia in animals including humans.

Figure 20 |

Figure 21 |

Figure 22 |
Subphylum Saccharomycotina contains approximately 1500 species of yeasts, most of which live as saprotrophs in association with plants and animals, but also including a small number of plant and animal pathogens (Suh et al. 2006). Asci are formed naked (Fig. 23)—not enclosed in a fruiting body. Yeasts traditionally have been important in the production of beer, wine, single cell protein and baker's yeast, but their role in industry has expanded to the production of citric acid, fuel alcohol, and riboflavin (Kurtzman and Sugiyama 2001).
Saccharomyces cerevisiae (Fig. 15), the yeast used in baking and brewing, is an important model organism for scientists studying a wide range of genetic and physiological processes. In 1997,
S. cerevisiae was the first eukaryotic organism to have its genome completely sequenced.

Figure 23
Subphylum Pezizomycotina is the largest group in the phylum, with more than 32,000 identified species that occupy a wide range of ecological niches, occurring as saprotrophs, parasites and mutualists with plants, animals and other fungi. At least 40% of the species form
lichens (Fig. 24). Three different types of asci occur in this subphylum, prototunicate, unitunicate and bitunicate. Prototunicate asci release ascospores by breakdown of the ascus wall, whereas in the unitunicate and bitunicate asci, the ascospores are forcibly discharged. Bitunicate asci have an inner wall that balloons out from the outer wall prior to ascospore discharge, and in unitunicate asci the wall layers do not separate from each other. A wide range of fruiting bodies are formed by members of subphylum Pezizomycotina, including
cleistothecia, chasmothecia, apothecia,
perithecia and
pseudothecia.
Stromata, hardened masses of hyphae on or in which perithecia or pseudothecia are formed, occur in some members of this subphylum.

Figure 24
Cleistothecia (sing. cleisothecium) (Fig. 25) lack a preformed opening and ascospores are released by the breakdown of the ascomatal wall. Common fungi that produce cleistothecia include the teleomorphic (sexual) states of
Aspergillus and
Penicillium (Fig. 26). Species of
Aspergillus are important in the production of fermented foods and beverages, including soy sauce, miso and rice wine (sake). Some species of
Aspergillus infect animals, causing a disease known as aspergillosis, and others produce mycotoxins. Aflatoxin is a potent carcinogen produced by
A. flavus that occurs in food made from cereals, corn and peanuts that have been colonized by the fungus. The U. S. Food and Drug Administration established a strict limit of 20 parts per billion on aflatoxin levels in food, and the U. S. spends $30-50 million annually on aflatoxin testing (Robens & Cardwell 2003).
Penicillium species are also used in food production. For example, the blue veins in Roquefort and Gorgonzola cheeses are due to the growth and sporulation of particular species of
Penicillium (Fig. 27), as is the white rind on the outside of Camembert cheese. The antibiotic penicillin, the "wonder drug" of the 20th century, is produced by strains of
P. chrysogenum (Raper, 1978). Other species of
Penicillium, such as
P. digitatum and
P. italicum cause the blue and green molds commonly causing rots of citrus fruits.

Figure 25 |

Figure 26 |

Figure 27 |
Chasmothecia (sing. chasmothecium) also lack a preformed opening, but ascospores are released by a split (or "chasm") in the ascomatal wall (Fig. 28). The term is now used to refer to the fruiting bodies of the powdery mildew fungi (Fig. 29) in order Erysiphales.

Figure 28 |

Figure 29 |
Apothecia (sing. apothecium) are exposed, often cup-shaped fruiting bodies (Fig. 30), but can take on a variety of forms, including those found in the morels (Morchella spp. Fig. 31). Apothecia-forming fungi are also called "cup fungi" or
discomycetes. Some important groups of plant pathogens that form apothecia include species of
Monilinia (brown rot of peach; Figs. 32 & 33), and
Sclerotinia.

Figure 30 |

Figure 31 |

Figure 32 |

Figure 33 |
Perithecia (sing. perithecium) are enclosed ascomata with a preformed opening (ostiole) through which ascospores are discharged (Fig. 34). Most fungi producing perithecia also have unitunicate asci and are classified in
Sordariomycetes, one of the largest classes of Ascomycota with more than 3,000 described species (Zhang et al. 2006). These fungi have also been called pyrenomycetes. Members of this group are common in nearly all ecosystems, where they occur as saprotrophs,
endophytes of plants, or pathogens of plants, animals and other fungi. A large number of economically important plant pathogens belong to Sordariomycetes, including those that cause anthracnose diseases (Glomerella cingulata), blasts
(Magnaporthe oryzae, rice blast pathogen), blights (Cryphonectria parasitica, chestnut blight),
ergot (Claviceps purpurea), and
Fusarium head blight (scab) of small grains (Gibberella zeae).

Figure 34
Pseudothecia (sing. pseudothecium) look similar to perithecia, but they differ in development. Asci form in locules (openings) inside vegetative fungal tissue called
ascostroma; this group has been called loculoascomycetes, but is now placed in class Dothideomycetes. Other characteristics of Dothideomycetes include the formation of bitunicate asci, and many members of this group produce darkly pigmented, multiseptate asospores or conidia. Similar to the Sordariomycetes, members of Dothideomycetes occur in a wide range of habitats as saprotrophs and associate with plants as pathogens, endophytes and growing on the surface of plants as
epiphytes (Schoch et al. 2006). Examples of well-known plant pathogens belonging to this group include
Venturia inaequalis (apple scab; Fig. 35) and
Mycosphaerellafijiensis (Black Sigatoka disease of banana); some of the common asexually reproducing fungi that belong in Dothideomycetes are
Alternaria (Fig. 36),
Cladosporium (Fig. 37), Phoma, and
Stemphylium.

Figure 35 |

Figure 36 |

Figure 37 |
Most of the lichen-forming members of Ascomycota belong in class Lecanoromycetes. This is the largest class of fungi, with over 13,500 described species (Miadlikowska et al. 2006). Most of the members of this class produce apothecial fruiting bodies (Figs. 7, 24, 38, 39). The majority of lichenized fungi form a symbiotic association with green algae, and approximately 10% are associated with cyanobacteria. The lichen thallus produces a wide range of secondary metabolites that are of biological and ecological importance (Miadlikowska et al. 2006). The lichen thallus is able to grow under a range of adverse conditions and some can survive for hundreds of years. Lichens are found in a wide range of habitats from the Arctic to Antarctic, including some species that can grow in aquatic and marine environments (Webster and Weber 2007).

Figure 38 |

Figure 39 |
Phylum Basidiomycota
Phylum Basidiomycota represents the second largest phylum of fungi, with nearly 30,000 described species. Members of phylum Basidiomycota produce
basidiospores on a typically club-shaped structure called a
basidium (Fig. 17). Characteristic of the mycelium of many members of Basidiomycota is the presence of
clamp connections (Figs. 40 & 41) and
dolipore septa.

Figure 40 |

Figure 41 |
Three main lineages are recognized in phylum Basidiomycota: subphyla Ustilaginomycotina, Pucciniomycotina, and Agaricomycotina (Blackwell et al. 2006). Ustilaginomycotina and Pucciniomycotina are composed mostly of plant parasitic species, known as
smut and
rust fungi, respectively, characterized by a state that produces thick-walled
teliospores (Figs. 42 & 43). The most extensively studied members of Ustilaginomycotina are species of
Tilletia and
Ustilago.
Ustilagomaydis, which causes
corn smut (Fig. 44), produces conspicuous tumor-like growths on infected host plants. These structures eventually become filled with dark teliospores and are considered a delicacy in Mexico called "cuitlacoche. " The most economically important species of
Tilletia are the
wheat bunts (T. caries and
T. laevis—common bunt;
T. contraversa—dwarf bunt; and
T. indica—Karnal bunt), plant pathogens that convert host ovaries into masses of dark, thick-walled teliospores that smell like rotting fish (Fig. 45).

Figure 42 |

Figure 43 |

Figure 44 |

Figure 45 |
Subphylum Pucciniomycotina include the group of plant parasites called rust fungi. The rust fungi are remarkable in having as many as five distinct types of spores in a single life cycle (spermatia, aeciospores, urediniospores, teliospores, and basidiospores) (Fig. 46 – general life cycle). Rust fungi that produce all five spore states are
macrocyclic, those that do not form uredinospores are
demicyclic, and those that do not form urediniospores and aeciospores are
microcyclic. Rust fungi may complete the life cycle on one host (autoecious rusts) or require two unrelated alternate hosts for completion of the life cycle (heteroecious rusts). The most widely cited example of a macrocyclic, heteroecious rust is
Puccinia graminis (black stem rust), which forms two spore states (uredinia and
telia) on cultivated wheat (Fig. 47) and two different spore states (spermagonia and
aecia) on barberry leaves (Fig. 48). The fifth state, the probasidium producing basidiospores, is formed upon germination of the teliospores (Fig. 46).

Figure 46 |

Figure 47 |

Figure 48 |
Subphylum Agaricomycotina, previously known as the Hymenomycetes, includes the morphologically diverse group of fungi that produce basidia in various types of fruiting bodies (Fig. 49 – general life cycle). This group includes the fungi commonly known as mushrooms (Fig. 50), puffballs (Fig. 51), shelf fungi (Fig. 52), stinkhorns (Fig. 53), jelly fungi (Figs. 54 & 55) and bird's nest fungi (Fig. 56). Many species are saprotrophic, utilizing dead plant material including woody substrates. Some of these saprotrophic species are cultivated for food, for example, the common button mushroom (Agaricusbisporus), oyster mushrooms (Pleurotusostreatus), and shiitake (Lentinulaedodes). Other members of this group are important ectomycorrhizal fungi, forming mutualistic associations with the roots of a wide range of trees. Some fruiting bodies produced by ectomycorrhizae are considered choice edibles, for example, chanterelles (Cantharelluscibarius and other species), porcini (Boletusedulis), and the American matsutake (Tricholoma magnivelare) (Fig. 6). A few members of this group are economically important plant parasites, e. g., species of
Armillaria and
Rhizoctonia.

Figure 49 |

Figure 50 |

Figure 51 |

Figure 52 |

Figure 53 |

Figure 54 |

Figure 55 |

Figure 56 |
Phylum Glomeromycota
The arbuscular mycorrhizal (AM) fungi, long considered to belong in the Zygomycota, are now recognized as comprising a distinct phylum, Glomeromycota (Shüβler et al. 2001). This is an ancient group of fungi, recognizable in the fossil record dating back at least 400 million years. The AM fungi form obligate, mutualistic associations, called
endomycorrhizae, with the roots of most (~80%) vascular plants. Only a small number (~160) of species is recognized in the phylum. One of the most distinctive features of these fungi is the highly branched
arbuscules formed inside the cortical cells of host roots; arbuscules are the point of exchange between fungus and plant, where carbohydrates produced by the plant are acquired by the fungus, and where nitrogen, phosphorous, and other minerals acquired by the mycelium of the fungus are transferred to the plant. The fungus acquires as much as 20-40% of the photosynthate produced by the plant. Some AM fungi also produce storage structures inside plant roots called
vesicles. Endomycorrhizal fungi produce an extensive network of hyphae outside the roots (extraradical hyphae). The extraradical hyphae act like an extension of the plant roots, increasing the plant's access to water and soil minerals, particularly phosphorous and nitrogen. The fungus is also able to access phosphate not otherwise available to plants, for example from organic matter by production of acid phosphatases. Reproduction of AM fungi is by thick-walled spores ranging in size from 40–800 µm in diameter, each of which can contain hundreds or thousands of nuclei. Spores may be formed singly or in clusters, and the mycelium of AM fungi is
coenocytic. Sexual reproduction is not known to occur in this phylum.
Phylum Chytridiomycota
"Chytrids" are a small group of fungi with approximately 900 identified species occurring in a wide range of aquatic and terrestrial habitats around the world. The feature that is shared by all members of this phylum is the formation of
zoospores with one posteriorly directed, whiplash
flagellum. A few chytrids are economically important plant pathogens, e. g.,
Synchytrium endobioticum, which causes the black wart disease of potato, others are vectors of plant viruses (Olpidium), but most are saprotrophs using substrates such as cellulose, chitin, and keratin as a food source. As previously noted, the frog chytrid,
Batrachochytrium dendrobatidis, has been implicated as a major factor in population declines of frogs and other amphibians around the world (Berger et al. 1998; Wake and Vredenburg 2008).
Phylum Zygomycota
This phylum contains approximately 900 identified species divided amongst two ecologically distinct classes, Zygomycetes and Trichomycetes (White et al. 2006). Hibbett et al. (2007) indicate the phylum is polyphyletic and further work is needed to clarify relationships of fungi traditionally considered in Zygomycota. The most commonly encountered Zygomycetes are members of orders Mortierellales and Mucorales. Many members of these two orders are saprotrophs with rapidly growing,
coenocytic mycelium. The sexual reproductive state is the
zygospore (Fig. 57 – general life cycle), but many of these fungi produce a large number of readily dispersed asexual spores called
sporangiospores. Members of order Mucorales, commonly called mucoraceous fungi, are common in soil, dung, plant material, and other types of organic matter. Some mucoraceous fungi are plant or animal pathogens, and others are used in the production of Asian foods such as tempeh. Species of
Mucor and
Rhizopus (Fig. 58) are commonly isolated from decaying organic matter and can cause decay diseases of fleshy fruits, vegetables, and sunflower peduncles.

Figure 57 |

Figure 58 |
Species of
Pilobolus (Figs. 59 & 60) are among the first fungi observed growing on herbivore dung incubated in moist chambers. Other Zygomycetes are associated with animals. For example, some species of
Rhizopus and
Mucor cause zygomycosis in immunocompromised humans. Entomophthorales, as the name suggests, include parasites of insects and other animals. Members of class Trichomycetes live in the guts of insects, millipedes, and crustaceans, but cause little or no harm to their hosts.

Figure 59 |

Figure 60 |
Fungal-like Organisms Studied by Plant Pathologists and Mycologists
Oomycetes
Oomycetes are fungal-like organisms that form zoospores with two flagella—a whiplash flagellum that is directed backwards and propels the zoospore, and a tinsel flagellum adorned with hairs that is directed forward, pulling the zoospore. The cell walls of Oomycetes contain cellulose, rather than chitin, and glucans. (Kirk et al., 2008). Another characteristic of Oomycetes is the formation of an
oospore, a thick-walled, resistant propagule which is the result of sexual reproduction. Oomycetes belong in Kingdom Straminipila, also known as Chromista. In addition to Oomycetes, this kingdom includes diatoms, golden and brown algae, a type of algae called cryptomonads, and two other groups of organisms studied by mycologists in phyla Labyrinthulomycota and Hyphochytriomycota. The tinsel type flagellum is a characteristic of all members of Kingdom Straminipila, hence it is also called a straminipilous flagellum.
Oomycetes include some of our most devastating plant pathogens.
These fungal-like organisms have changed the course of history. Consider 19th century Ireland; life was hard for the millions of Irish in the 1840s who relied almost entirely upon the "lumper" potatoes they grew on leased quarter-acre plots for food and rent. It's said that the stomachs of these "cottiers" were distended from eating up to fourteen pounds of potatoes
each day (Large 1940). Then, in 1845, the potatoes began to rot from a malady known as "Potato Murrain," what we now call
late blight of potato. Without potatoes, 4. 5 million Irish faced starvation. Over the next 15 years, one million Irish died from the famine, and one and a half times that number fled Ireland. Late blight is caused by
Phytophthora infestans, and this oomycete continues to be a major pathogen in potato production, although we now have the ability to control it through the application of fungicides.
A number of other important plant pathogens are found among the Oomycetes, but only a few will be mentioned here.
Phytophthora ramorum causes
sudden oak death and ramorum blight.
Pythium species cause damping-off diseases under extremely wet conditions. Seedlings are particularly vulnerable to attack by damping-off pathogens because their tissues are soft and easily invaded. Seedlings may be killed before or after they emerge from the soil. Downy mildews (Peronosporales) are biotrophic Oomycetes that are characterized by the formation of white, downy sporangiophores on the surface of infected hosts. The
white rusts (Albugo spp. ) produce chains of sporangia that erupt through the cuticle of infected hosts.
Albugo species parasitize crucifers and produce blister-like pustules filled with sporangia, which will germinate to produce motile zoospores. White rusts can also cause infected stems to grow in a contorted or twisted manner.
Members of Saprolegniales are called water molds. Many of these produce fast-growing, robust hyphae on organic matter in aquatic environments, but some species of
Saprolegnia are parasitic on fish and fish eggs. For more information on Oomycetes, see
Introduction to Oomycetes (Fry & Grünwald 2010).
Other groups
Labyrinthulids (phylum
Labyrinthulomycota), a small group of Straminipila, include organisms that cause rapid blight of turf grass and the wasting disease of eelgrass. Labyrinthulids have a unique manner of movement—their microscopic, football-shaped cells produce an ectoplasmic net through which the cells glide. The slow, gliding movement of the cells within the ectoplasmic net can be observed under the microscope.
Hyphochytrids (phylum
Hyphochytridomycota, Kingdom Straminipila) are similar to chytrids in appearance, as their name suggests, and produce zoospores with a single anterior tinsel flagellum. Hyphochytrids are one of the smallest groups of fungal-like organisms, both in size and in number of species with only 23 known. Some hyphochytrids are known to parasitize algae, spores of AM fungi, and oospores of Oomycetes.
Slime molds
Slime molds are organisms that have a trophic (feeding) stage in their life cycle that lacks a cell wall, either uninucleate (amoeba) or multinucleate (plasmodium). The lack of a cell wall facilitates engulfment of food, in contrast to true fungi that must absorb their nutrients through a cell wall. The slime molds are now included in the Amoebozoa (Adl et al. 2005).
Four groups of slime molds are recognized—plasmodial slime molds (Myxomycota), cellular slime molds (Dictyosteliomycota and Acrasiomycota) and endoparasitic slime molds (Plasmodiophoromycota). We will briefly cover plasmodial slime molds and endoparasitic slime molds. For information on cellular slime molds, refer to one of the introductory mycology texts listed below (Recommended Further Reading). The plasmodial slime molds are most commonly found in temperate forests, where they occur on plant litter, tree bark, and other types of plant material. They produce a multinucleate trophic stage lacking a cell wall called a
plasmodium (Fig. 61) that moves over and through decaying organic matter, engulfing bacteria, fungi, and other microorganisms (Frederick 1990). The most conspicuous stage of the plasmodial slime mold is the fruiting structures, called sporophores (Alexopoulos et al. 1996), which are often brightly colored and visible to the naked eye (Fig. 62). One of the most common slime molds in temperate regions is
Fuligo septica. The sporophores of this slime mold are often found in ornamental bark and mulch, and look more like an animal's vomit than the fruiting structure of a living organism, thus earning the nickname: "dog vomit slime" (Fig. 63). The presence of slime molds in landscaping (Fig. 64) occasionally prompts calls to plant disease clinics, however, none of the plasmodial slime molds are known to be plant or animal parasites, and are of no known economic importance except as model organisms for research.

Figure 61 |

Figure 62 |

Figure 63 |

Figure 64 |
Members of phylum
Plasmodiophoromycota are biotrophic parasites that produce their plasmodial stage inside the cells of plants, algae, diatoms, and Oomycetes. Several members of this phylum are economically important plant parasites, including
Plasmodiophora brassicae, which causes clubroot of crucifers (Fig. 65) and
Spongospora subterranea, which causes powdery scab of potato (Fig. 66).
Polymyxa graminis is a vector for soilborne wheat mosaic virus, an economically important disease of wheat. Members of this phylum produce cysts inside host cells; the cysts are released when the plant tissue breaks down, and germinate to release a zoospore that infects the host by injecting its cytoplasm into a host cell. Infected host tissue may become greatly swollen as in clubroot of crucifers.

Figure 65 |

Figure 66 |
A Brief Summary
As we have seen, a fungus is a eukaryotic organism that absorbs nutrients through its cell walls and generally reproduces by sporesTrue fungi belong to Kingdom Fungi, and other fungal-like organisms are placed in phyla outside the Kingdom Fungi. Most fungi consist of a hyphal thallus that allows these organisms to colonize and exploit many different substrates and fill various ecological niches, as parasites, pathogens, mutualists, saprotrophs and decomposers. Fungi and fungal-like organisms survive and reproduce via a huge diversity of spore types, characteristic of each taxonomic group. This introduction has provided some basic information on reproduction, nutrient acquisition, and roles in the ecosystem, but much more information is available (see Recommended Further Reading and the References). Fungi are fascinating in and of themselves, but they are also critically important to humans in both detrimental and beneficial ways.
Recommended Further Reading
For more information on fungi, popularized accounts by Hudler (1998), Money (2002, 2007), and Moore (2001) are good sources of information written in an engaging manner. Introductory mycology books by Alexopoulos et al. (1996), Deacon (2006), Kendrick (2000), Moore et al. (2011), and Webster and Weber (2007) provide more detailed information on fungi than can be included in this brief introduction. Tales of fungi, folklore, and human affairs can be found in Dugan (2008) and Findlay (1982), and an engaging book on the impact of fungal plant pathogens by Money (2007). A number of books on hallucinogenic/psychoactive mushrooms have been written, some describing the history of these intriguing mushrooms. Gordon Wasson's (1968) book "Soma" is one of the first ethnomycological treatments of hallucinogenic mushrooms, and a recent book on the history of magic mushrooms by Letcher (2007) relays the story of their use from ancient Aztecs to contemporary society.
Acknowledgments
We thank APS Press for allowing us to use images from "Fundamental Fungi. "All other images used with permission. We thank a number of colleagues who have kindly provided us with images. PPNS No. 0572, Department of Plant Pathology, College of Agriculture, Human, and Natural Resource Sciences, Agricultural Research Center, Project No WNP0837, Washington State University, Pullman, WA99164-6430, USA. This paper is Contribution No. 11-288-J from the Kansas Agricultural Experiment Station, Manhattan.
References
Adl, S., A. Simpson, M. Farmer, R. Andersen, O. Anderson, J. Barta, J. et al. 2005. The new higher level classification of eukaryotes with emphasis on the taxonomy of protists. Journal of Eukaryotic Microbiology, 52(5), 399-451. DOI:10.1111/j.1550-7408.2005.00053.x.
Alexopoulos, C.J., C.W. Mims, and M. Blackwell. 1996.Introductory Mycology. Fourth Edition. John Wiley & Sons Inc., New York.
Barron, G.L. 1977.The Nematode-Destroying Fungi.Canadian Biological Publications, Guelph, ON.
Berger, L., R. Speare, P. Daszak, D.E. Green, A.A. Cunningham, C.L. Goggin, R. Slocombe, M.A. Ragan, A.D. Hyatt, K.R. McDonald, H.B. Hines, K.R. Lips, G. Marantelli, and H. Parkes. 1998. Chytridiomycosis causes amphibian mortality associated with population declines in the rain forests of Australia and Central America. Proceedings of the National Academy of Sciences USA 95:9031-9036.
Blackwell, M.2011. The Fungi: 1, 2, 3…5.1 million species?American Journal of Botany 98:426-438.
Blackwell, M., D.S. Hibbett, J.W. Taylor, and J.W. Spatafora. 2006. Research Coordination Networks: a phylogeny for kingdom Fungi (Deep Hypha).Mycologia 98:829-837.
Blackwell, M., R. Vilgalys, T.Y. James, and J.W. Taylor. 2012. Fungi. Eumycota: mushrooms, sac fungi, yeast, molds, rusts, smuts, etc. Version 30 January 2012.
http://tolweb.org/Fungi/2377/2012.01.30 in The Tree of Life Web Project,
http://tolweb.org/
Blehert, D.S., A.C. Hicks, M. Behr, C.U. Meteyer, B.M. Berlowski-Zier, E.L. Buckles, J.T.H. Coleman, S.R. Darling, A. Gargas, R. Niver, J.C. Okoniewski, R.J. Rudd, and W.B. Stone. 2009. Bat white-nose syndrome: An emerging fungal pathogen? Science 323:227.
Boerjan, W., J. Ralph, and M. Baucher. 2003.Lignin biosynthesis.Annual Review of Plant Biology 54:519-546.
Bromenshenk, J.J., C.B. Henderson, C.H. Wick, M.F. Stanford, A.W. Zulich, et al. 2010. Iridovirus and Microsporidian linked to Honey Bee Colony Decline. PLoS ONE 5(10): e13181. DOI:10.1371/journal.pone.0013181.
Callan, B.E. and L.M. Carris 2004. Fungi on living plant substrata, including fruits. Chap. 7 in: G.M. Mueller, G.F. Bills, and M.S. Foster, eds. Biodiversity of Fungi. Inventory and Monitoring Methods. Elsevier Academic Press, San Diego, CA.
Deacon, J. 2006. Fungal Biology. Fourth Edition. Blackwell Publishing, Malden, MA.
Dugan, F.M. 2008.Fungi in the Ancient World.How Mushrooms, Mildews, Molds, and Yeast Shaped the Early Civilizations of Europe, the Mediterranean, and the Near East.APS Press, St. Paul, MN.
Duplessis, S. et al. (49 additional authors). 2011.Obligate biotrophy features unraveled by the genomic analysis of rust fungi.Proceedings of the National Academy of Sciences U.S.A. 108:9166-9171.
Evans, H.C., S.L. Elliot, and D.P. Hughes. 2011.Hidden diversity behind the zombie-ant fungus
Ophiocordyceps unilateralis Four new species described from carpenter ants in Minas Gerais, Brazil.PLoS ONE 6: e17024.DOI:10:1371/journal.pone.0017024.
Findlay, W.P.K. 1982. Fungi, Folklore, Fiction and Fact. The Richmond Publishing Co, Surrey, BC.
Frederick L. 1990. Phylum Plasmodial Slime Molds. Class Myxomycota. Chapter 27a in: L. Margulis, J.O. Corlis, M. Melkonian, and D.J. Chapman, eds. Handbook of Protoctista. Jones and Bartlett Publishers, Boston, MA.
Fry, W.E. and N.J. Grünwald. 2010. Introduction to Oomycetes. The Plant Health Instructor. DOI:10.1094/PHI-I-2010-1207-01.
Hawksworth, D.L. 2001. The magnitude of fungal diversity: the 1.5 million species estimate revisited. Mycological Research 105:1422-1432.
Hawskworth, D.L. and A.Y. Rossman. 1997. Where are all the undescribed Fungi? Phytopathology 87:888-891.
Hibbett, D.S., M. Binder, and Z. Wang.2003.Another fossil agaric from Dominican amber. Mycologia 95:685-687.
Hibbett, D.S. et al. (66 additional authors). 2007. A higher-level phylogenetic classification of the Fungi. Mycological Research 111:509-547.
Hudler, G.W. 1998.Magical Mushrooms, Mischievous Molds. The Remarkable Story of the Fungus Kingdom and its Impact on Human Affairs. Princeton University Press, Princeton, NJ.
Hughes, D.P., S. Anderson, N.L. Hywel-Jones, W. Himaman, J. Billen, and J.J. Boomsma.2011.Behavioral mechanisms and morphological symptoms of zombie ants dying from fungal infection.BMC Ecology 11:13.DOI:10.1186/1472-6785-11-13.
Jones, M.D.M., I. Forn, C. Gadelha, M.J. Egan, D. Bass, R. Massana, and T.A. Richards.2011.Discovery of novel intermediate forms redefines the fungal tree of life.Nature 474:200-203.DOI:10.1038/nature09984.
Keeling, P., B.S. Leander, and A. Simpson. 2009. Eukaryotes. Eukaryota, Organisms with nucleated cells. Version 28 October 2009.
http://tolweb.org/Eukaryotes/3/2009.10.28 in The Tree of Life Web Project,
http://tolweb.org
Kendrick, B. 2000.The Fifth Kingdom.Third Edition.Focus Publishing, Newburyport, MA.
Kirk, P.M., P.F. Cannon, D.W. Minter, and J.A. Stalpers, eds. 2008. Dictionary of the Fungi. 10th Edition. CAB International, Wallingford, UK.
Kurtzman, C.P. and J. Sugiyama. 2001. Ascomycetous yeasts and yeastlike fungi. Chap. 9 in: D.J. McLaughlin, E.G. McLaughlin, and P.A. Lemke, eds. The Mycota . Vol. VII. Systematics and Evolution Part A. Springer-Verlag, Berlin.
Large, E.C. 1940. The Advance of the Fungi. H. Holt and Company, New York. (Republished by APS Press, http://www.apsnet.org/apsstore/shopapspress/Pages/43089.aspx)
Letcher, A. 2007. Shroom. A Cultural History of the Magic Mushroom. Harper Collins, New York.
Longcore, J.E., A.P. Pessier, and D.K. Nichols, D. K.1999.
Batrachochytrium dendrobatidis gen. et sp. nov., a chytrid pathogenic to amphibians.Mycologia 91:219-227.
Miadlikowska, J. et al. (29 additional authors). 2006. New insights into classification and evolution of the Lecanoromycetes (Pezizomycotina, Ascomycota) from phylogenetic analyses of three ribosomal RNA- and two protein-coding genes. Mycologia 98:1088-1103.
Money, N.P. 2002.Mr. Bloomfield's Orchard. The Mysterious World of Mushrooms, Molds, and Mycologists.Oxford University Press, New York.
Money, N.P. 2007.The Triumph of Fungi.A Rotten History.Oxford University Press, New York.
Moore, D. 2001. Slayers, Saviors, Servants, and Sex.An Exposé of Kingdom Fungi.Springer, New York.
Moore, D., G.D. Robson, and A.P.J. Trinci. 2011.21st Century Guidebook to Fungi.Cambridge University Press, New York.
Nagarajan, S. and D.V. Singh.1990.Long-distance dispersion of rust pathogens.Annual Review of Phytopathology 28:139-153.
Parfrey, L.W., D.J.G Lahr, A.H. Knoll, L.A. Katz.2011.Estimating the timing of early eukaryotic diversification with multigene molecular clocks.Proceedings of the National Academy of Sciences USA. 108:13624-13629.
Ploetz, R.C. 2001. Black Sigatoka of Banana. The Plant Health Instructor. DOI:10.1094/PHI-I-2001-0126-01.
Ploetz, R.C. 2005. Panama disease, an old nemesis rears its ugly head: Part 1, the beginnings of the banana export trades. Online. Plant Health Progress DOI:10.1094/PHP-2005-1221-01-RV.
Purvis, A. and A. Hector. 2000. Getting the measure of biodiversity. Nature 405:212-219.
Raper, K.B.1978. The penicillin saga remembered. American Society of Microbiology News 44:645-653.
Redecker, D., R. Kodner, L.E. Graham. 2000. Glomalean fungi from the Ordovician. Science 289:1920-1921.
Robens, J. and K. Cardwell.2003.The costs of mycotoxin management to the USA: Management of aflatoxins in the United States.Journal of Toxicology-Toxin Reviews 22:139-152.
Rodriguez, R.J., J.F. White Jr., A.E. Arnold, and R.S. Redman.2009.Fungal endophytes: diversity and functional roles.New Phytologist 182:314-330.
Schoch, C. L., R.A. Shoemaker, K.A. Seifert, S. Hambleton, J.W. Spatafora, and P.W. Crous. 2006.A multigene phylogeny of the Dothideomycetes using four nuclear loci.Mycologia 98:1041-1052.
Shüβler, A., D. Schwarzott, C. Walker. 2001. A new fungal phylum, the Glomeromycota: phylogeny and evolution. Mycological Research 105:1413-1421.
Spanu, P.D. et al. (63 additional authors) 2010.Genome expansion and gene loss in powdery mildew fungi reveal tradeoffs in extreme parasitism.Science 330:1543-1546.
Stover, C.K. et al. (30 additional authors). 2000. Complete genome sequence of
Pseudomonas aeruginosa PA010, an opportunistic human pathogen. Nature 406:959-964.
Suh, S.-O., M. Blackwell, C.P. Kurtzman, and M.-A. Lachance. 2006. Phylogenetics of Saccharomycetales, the acomycete yeasts. Mycologia 98:1006-1017.
Voyles, J., S. Young, L. Berger, C. Campbell, W.F. Voyles, A. Dinudom, D. Cook, R. Webb, R.S. Alford, L.F. Skerratt, and R. Speare. 2009. Pathogenesis of chytridiomycosis, a cause of catastrophic amphibian declines. Science 326:582-585.
Wake, D.B. and V.T. Vredenburg, V.T. 2008. Are we in the midst of the sixth mass extinction? A view from the world of amphibians. Proceedings of the National Academy of Sciences USA 105:11466-11473.
Wasson, R.G.1968. Soma: Divine Mushroom of Immortality. Harcourt Brace Jovanovich, New York.
Webster, J. and R.W.S. Weber. 2007. Introduction to Fungi. Cambridge University Press, New York.
White, M.M., T.Y. James, K. O'Donnell, M.J. Cafaro, Y. Tanabe, and J. Sugiyama. 2006. Phylogeny of the Zygomycota based on nuclear ribosomal sequence data. Mycologia 98:872-884.
Zhang, N., L.A. Castlebury, A.N. Miller, S.M. Huhndorf, C. Schoch, K.A. Seifert, A.Y. Rossman, J.D. Rogers, J. Kohlmeyer, B. Volkmann-Kohlmeyer, and G.-H Sung. 2006. An overview of the systematics of the Sordariomycetes based on a four-gene phylogeny. Mycologia 98:1076-1087.
Zolan, M.E. 1995. Chromosome-length polymorphism in fungi. Microbiological Reviews 59:686-698.
